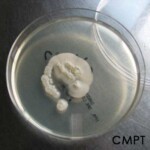
culture of candida krusei on saboureaud agar
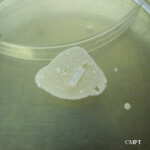
candida parapsilosis culture in saboureaud agar
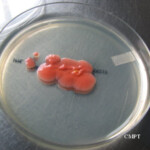
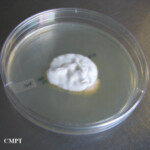
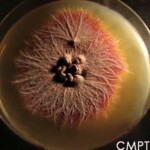
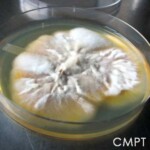
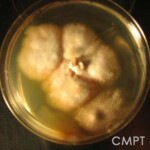
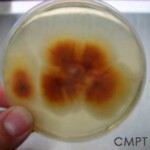
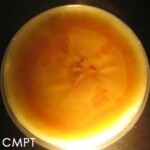
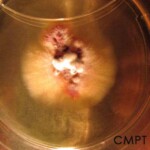
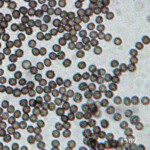
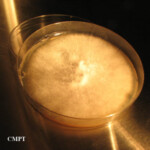
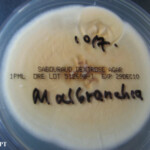
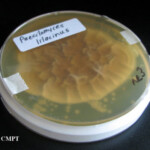
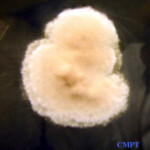
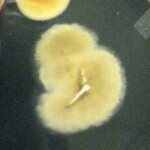
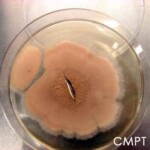
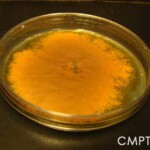

The content and images on our website is protected by copyright and intellectual property laws. Using and/or downloading the site content for commercial uses or distribution is prohibited. Any displays or printout of the site content should be credited to CMPT.
HYPHOMYCETES (dematiaceous)
- Alternaria species
- Bipolaris species
- Cladosporium species TOP
- Rhinocladiella species
- Stachybotrys species